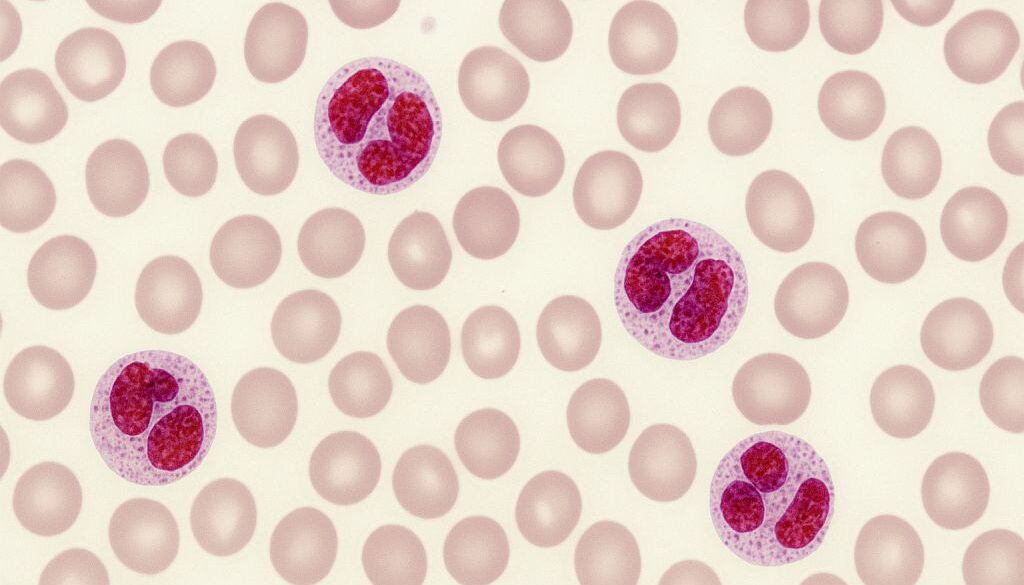
Eozynofilia Warszawa

Eozynofilia Warszawa – kiedy podwyższony poziom eozynofilów powinien niepokoić?
Podwyższona liczba eozynofilów we krwi może być sygnałem poważniejszych problemów zdrowotnych. Sprawdź, czym jest eozynofilia, jakie są jej przyczyny i kiedy warto skonsultować się z lekarzem w MCM Wiktorska w Warszawie.
Czym jest eozynofilia?
Eozynofilia to stan, w którym liczba eozynofilów – jednego z typów białych krwinek – przekracza przyjęte normy. Fizjologicznie eozynofile odpowiadają za reakcje obronne organizmu, zwłaszcza w kontekście infekcji pasożytniczych oraz reakcji alergicznych. Kiedy jednak ich poziom staje się zbyt wysoki, może świadczyć o toczących się w organizmie procesach zapalnych, chorobach autoimmunologicznych lub nowotworach układu krwiotwórczego. W praktyce klinicznej przyjmuje się, że eozynofilia rozpoznawana jest wtedy, gdy stężenie eozynofilów w morfologii krwi obwodowej przekracza 500 komórek/µl.
Przyczyny eozynofilii – co może ją wywoływać?
Najczęstszym powodem podwyższonego poziomu eozynofilów są alergie, w tym astma oskrzelowa, alergiczny nieżyt nosa czy atopowe zapalenie skóry. Kolejną grupą są choroby pasożytnicze, rzadziej spotykane w naszej szerokości geograficznej, ale wciąż obecne, zwłaszcza u osób podróżujących do krajów tropikalnych. Warto także pamiętać o reakcjach polekowych – niektóre antybiotyki, leki przeciwdrgawkowe czy niesteroidowe leki przeciwzapalne mogą powodować wzrost liczby eozynofilów. Nie można również pominąć chorób hematologicznych, takich jak przewlekła białaczka eozynofilowa czy zespoły mielodysplastyczne, gdzie eozynofilia może być jednym z pierwszych objawów procesu nowotworowego. Wreszcie, eozynofilia towarzyszy również chorobom autoimmunologicznym, na przykład zapaleniu naczyń czy toczniowi układowemu.
Jakie objawy mogą towarzyszyć eozynofilii?
Podwyższony poziom eozynofilów nie zawsze daje charakterystyczne objawy. Często bywa wykrywany przypadkowo podczas rutynowego badania krwi. Jeśli jednak towarzyszą mu inne symptomy, takie jak przewlekły kaszel, świąd skóry, wysypki, powiększenie węzłów chłonnych, bóle mięśni lub stawów, warto skonsultować się z lekarzem w naszej placówce w Warszawie. Takie objawy mogą wskazywać na chorobę podstawową, która wymaga dalszej diagnostyki. W skrajnych przypadkach, gdy eozynofilia osiąga bardzo wysokie wartości, może dojść do uszkodzenia narządów – najczęściej serca, płuc lub układu nerwowego – w wyniku odkładania się eozynofilów w tkankach.
Diagnostyka eozynofilii w MCM Wiktorska w Warszawie
W diagnostyce eozynofilii nie wystarczy jedynie wykonanie morfologii krwi. Nadrzędne jest znalezienie przyczyny tego stanu. Lekarz może zlecić dodatkowe badania, takie jak rozmaz krwi obwodowej, oznaczenie przeciwciał IgE, badania w kierunku pasożytów, testy alergiczne czy badania obrazowe. W niektórych przypadkach konieczna jest biopsja szpiku kostnego, aby wykluczyć choroby nowotworowe układu krwiotwórczego. W MCM Wiktorska w Warszawie oferujemy kompleksową opiekę diagnostyczną i współpracę lekarzy różnych specjalności, co pozwala na szybkie i trafne postawienie rozpoznania.
Leczenie eozynofilii – od przyczyny do skutecznej terapii
Postępowanie w przypadku eozynofilii zawsze wymaga indywidualnego podejścia. Nie leczy się samego podwyższonego poziomu eozynofilów, lecz jego przyczynę. Jeśli powodem jest alergia, włączane są leki przeciwhistaminowe, czasem glikokortykosteroidy, a także leczenie objawowe. W przypadku chorób pasożytniczych stosuje się odpowiednie preparaty przeciwpasożytnicze. Gdy źródłem problemu są nowotwory krwi lub choroby autoimmunologiczne, leczenie prowadzone jest w porozumieniu z hematologiem lub reumatologiem. W MCM Wiktorska w Warszawie pracujemy zespołowo, aby pacjent otrzymał pomoc dopasowaną do swojego stanu zdrowia, co pozwala uniknąć powikłań związanych z długotrwałą eozynofilią.
Kiedy zgłosić się do lekarza?
Każdy niepokojący wynik morfologii krwi, w tym podwyższony poziom eozynofilów, warto skonsultować z internistą lub hematologiem. Dotyczy to zwłaszcza sytuacji, gdy pojawiają się dodatkowe objawy: gorączka, utrata masy ciała, osłabienie czy duszność. W naszym centrum medycznym w Warszawie pacjent może liczyć na pełną diagnostykę oraz wsparcie w dalszym leczeniu. Zachęcamy, aby nie bagatelizować sygnałów płynących z organizmu – wczesna konsultacja może znacząco poprawić rokowanie w przypadku chorób, które objawiają się eozynofilią.
Eozynofilia Warszawa – profesjonalna diagnostyka i opieka w MCM Wiktorska
Jeśli zauważyłeś nieprawidłowy wynik badania krwi lub masz objawy, które mogą sugerować eozynofilię, umów się na wizytę w MCM Wiktorska w Warszawie. Nasz zespół alergologów zapewnia rzetelną diagnostykę, indywidualne podejście oraz opiekę opartą na najnowszych standardach medycyny. Dzięki nowoczesnym metodom diagnostycznym możemy szybko wykryć przyczynę zaburzeń i zaproponować skuteczne leczenie. Skontaktuj się z nami i zadbaj o swoje zdrowie już dziś – bo właściwa diagnoza to pierwszy krok do skutecznej terapii.